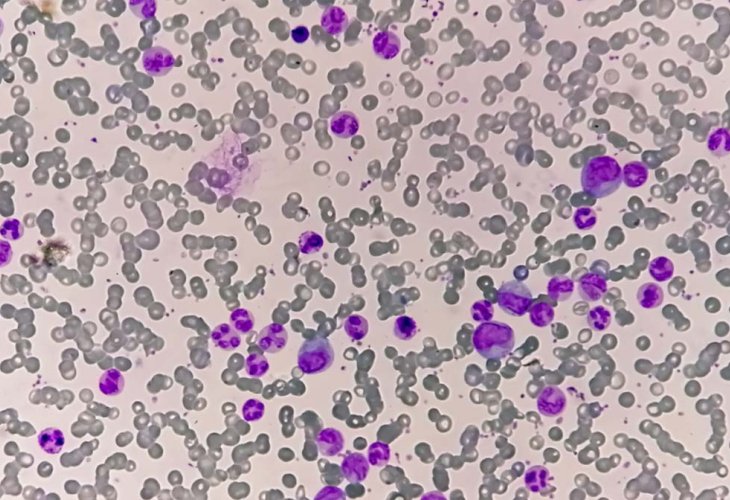

From Incurable to Chronic: Everything You Need to Know About Chronic Myeloid Leukemia (CML)
How is Chronic Myeloid Leukemia diagnosed, and how did it transition from a fatal disease to a manageable chronic condition?
(Photo: shutterstock)
(Photo: shutterstock)Until about 20 years ago, Chronic Myeloid Leukemia (CML) was considered incurable with limited treatment options. In the early 2000s, a novel treatment was introduced that transformed how the disease is managed, allowing patients to live with it. However, there are still patients for whom the treatment is ineffective or unsuitable, but now there is a solution available for them as well.
Chronic Myeloid Leukemia (CML) is a type of cancer originating from the blood-producing bone marrow cells, leading to an excessive production of mature white blood cells. Typically, the disease progresses slowly, although it can occasionally develop into acute leukemia.
About 15% of adult leukemia cases are of the CML type, and roughly half of those affected are 65 years or older. According to the American Cancer Society, approximately 8,000 new cases are diagnosed each year in the U.S.
People with CML develop a defect over their lifetime, leading to the creation of a short chromosome known as the Philadelphia chromosome. This chromosome alters a specific gene (BCR-ABL) in a way that impairs its function—a sort of "on switch" that causes an overproduction of granulocytes, a type of white blood cell. Once these granulocytes proliferate and accumulate in the blood and bone marrow, there's not enough room for healthy blood cells to grow. Eventually, leukemia cells migrate from the bone marrow to other organs, such as the spleen.
Chronic Myeloid Leukemia is called "chronic" because the cells partially mature but not completely and live longer than healthy cells. It may take some time before this type of leukemia presents problematic symptoms, but chronic forms of leukemia are generally more challenging to treat.
How is the disease diagnosed?
In Chronic Myeloid Leukemia (CML), there is a malignant increase of white blood cells in the blood resulting from changes in these cells' chromosomes, which occur for unknown reasons unrelated to genetic or familial causes. The disease-causing chromosome was discovered in the 1960s in a Philadelphia laboratory, thus called the Philadelphia chromosome.
Most patients discover the disease during a routine blood test or for other reasons. Test results may show an elevated white blood cell count, even though patients often do not exhibit symptoms. At this point, the blood test is sent for comprehensive evaluation, including a complete blood count (CBC) and blood smear to check cell quality, as well as a PCR blood test for genetic changes. Subsequently, an appointment with a hematologist and a bone marrow test to determine the disease stage and complete genetic tests are conducted. Detection at this stage is crucial, as it's the starting point of available wide-ranging treatment options to prevent disease progression.
Additional signs that may emerge during the chronic stage include an enlarged spleen leading to upper left abdominal pain, early satiety, an enlarged liver, anemia, and general symptoms like loss of appetite, weight loss, night sweats, and low fever. This stage can last on average 3-4 years, but can range from months to many years. As mentioned, this is critical for diagnosis as only at this stage can the progression be halted.
The Accelerated Phase
The accelerated phase of the disease is perilous, as available treatments are fewer and less effective compared to the chronic phase. Most cases exhibit a pre-phase where the patient feels bone pain, fever, weight loss, rapid spleen enlargement, and uncontrollable increase of white blood cells, among other symptoms that characterize this phase. This can last several months to years and heralds the arrival of the disease's terminal stage known as the blast crisis.
The Blast Crisis
The blast crisis is acute leukemia by all accounts. This phase is defined by the presence of over 20% malignant cells in the peripheral blood or bone marrow. At this stage, the disease must be treated like acute leukemia, but it's important to note that the patient’s cure prospects are significantly lower than for a typical acute leukemia without preexisting conditions. The prognosis for this stage is dire, with survival typically ranging from three to six months despite treatment response and undergoing a bone marrow transplant.
How is the disease treated?
The transformation in the nature of CML and the ability to live alongside it lies in innovative treatments developed in recent years. The development of targeted therapies combating the cancer-causing factor in CML now allows most patients to continue with their lives. Targeted therapy utilizes drugs that identify and attack specific leukemia cells without harming healthy cells. Patients newly diagnosed with chronic phase CML are often treated with tyrosine kinase inhibitors (TKIs) that specifically target the BCR-ABL gene. In most cases, this targeted treatment is effective. Some individuals can achieve a deep molecular response with TKIs and discontinue treatment. Recently, a new drug with a novel mechanism and high efficacy has been developed, providing an effective treatment option for these patients without compromising safety.
Dr. Yulia Wolchick is the head of Myeloproliferative Services at Sheba Medical Center.
 עברית
עברית

